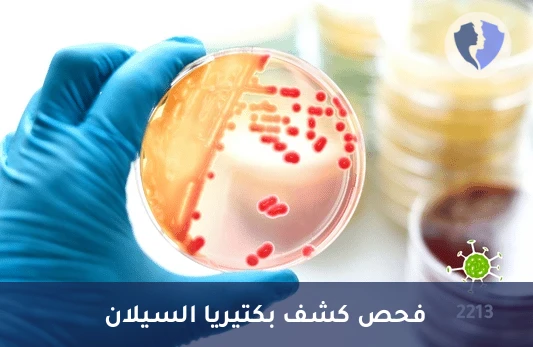
فحص السيلان المجهري السريع - فحص مسحة بكتيريا السيلان (Neisseria gonorrhoeae)

تفاصيل الخدمة
فحص السيلان المجهري السريع - فحص مسحة بكتيريا السيلان (Neisseria gonorrhoeae)
فحص مجهري مباشر لعينات الإفرازات باستخدام تقنيات صبغ خاصة (صبغة الغرام) للكشف عن بكتيريا النيسرية البنية (Neisseria gonorrhoeae). تظهر البكتيريا بشكل مكورات ثنائية سالبة لصبغة الغرام داخل خلايا الدم البيضاء.